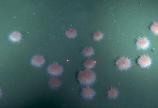

Sea urchins are on the move, and the ‘Blob’ is partly to blame

New research has uncovered a change in behaviour of deep-sea fragile pink sea urchins off the south coast of Vancouver Island that is linked to climate change impacts including the “ Blob,” a marine heatwave that persisted in the Pacific Ocean off North America between 2013 to 2016.
Researchers from the Memorial University, Ocean Networks Canada (ONC) and the University of Victoria (UVic) found pink sea urchins ( Strongylocentrotus fragilis) have been moving up into shallower waters as food sources and oxygen levels at lower depths decline due to a warming ocean.
The research team analyzed seven years of physicochemical and video imagery data (2013-2020) collected at Barkley Canyon Upper Slope within ONC’s NEPTUNE observatory, along with 14 years of Fisheries and Oceans Canada trawl surveys, covering a 760-square kilometre area in the northeast Pacific Ocean. The data from NEPTUNE’s Barkley Canyon Upper Slope platform (depth 396 metres) included video cameras, oxygen sensors, and tools that monitor water currents and water physical properties.
A map of the study area showing the NEPTUNE cabled observatory infrastructure at Barkley Canyon Upper Slope. Credit: Ocean Networks Canada
By analyzing data before, during, and after the Blob marine heat wave, they found that, on average, the pink urchins moved up to 49 vertical metres into shallower water at a rate of 3.5-metres per year.
Rylan Command, lead author from Memorial University and UVic Faculty of Science alumni, says kelps have been slow to recover from recent heat waves along the BC coast, posing challenges for many species including bottom-dwelling sea urchins, which rely on decaying kelp for food.
Lead author and UVic-alumni, Rylan J. Command, Fisheries and Marine Institute, Memorial University of Newfoundland. Credit: Rylan J. Command
The warmer-than-normal surface temperatures inhibits a natural “ocean mixing’ process called upwelling, when nutrient rich water from lower depths cycles up to mix with warmer, surface waters which influences how much kelp and seaweed grow.
Command says another factor behind urchins’ relocation could be respiratory, with warming ocean temperatures being linked to the expansion of the ocean’s oxygen minimum zone where dissolved O2 levels are naturally low due to poor ventilation and microbial respiration.
“Marine organisms can tolerate variability in dissolved oxygen within a certain range. But as the oxygen minimum zone expands, habitat that was previously suitable may no longer have enough oxygen for some organisms to survive,” he says.
The paper’s findings are consistent with previous research off California’s continental margin linking expanding deoxygenation within the water column to urchin migration there.
Four years after the Blob dissipated, video footage at Barkley Upper Slope showed that the urchins were returning. However, in the long term, the researchers expect that pink urchins will continue to move into shallow water as the Northeast Pacific oxygen minimum zone continues to expand, and climate change increases the frequency of marine heat waves.
The researchers say this adaptation by sea urchins may have a long-lasting effect on the wider coastal ecosystem as well as economic impacts.
Image of deep-sea fragile pink sea urchins, Strongylocentrotus fragilis, captured by the Barkley Canyon Upper Slope observatory camera. Credit: Ocean Networks Canada
Command says it could affect the abundance and distribution of shallow water red sea urchins ( Mesocentrotus franciscanus) and green sea urchins ( Strongylocentrotus droebachiensis), both of which are fisheries species.
Pink sea urchins also play a key role in cycling nutrients in the water column, by stirring up ocean floors, known as bioturbation, as well as feeding on decayed organic material. Changes in the density and distribution of this species may directly affect sediment turnover rates and nutrient cycling on the continental margin, with consequences for surface and coastal productivity.
Co-author and ONC senior scientist Fabio De Leo says this work highlights the value of combining multiple data sources to tell a holistic story of how underwater species respond to ocean change over time.
Co-author & ONC Senior Scientist, Fabio De Leo Credit: Ocean Exploration Trust
“This study shows the importance of long oceanographic data time-series not only in coastal areas but also in the deep-sea. ONC has now accumulated nearly 14 years of observations at the seafloor in Barkley Canyon, which is helping us better understand how individual species and entire ecosystems are responding to the effects of climate change.”
NEPTUNE (North East Pacific Time-series Undersea Networked Experiments) observatory is a large, seafloor cabled network that powers thousands of scientific sensors off Canada’s west coast.
ONC’s infrastructure collects continuous data on our shifting ocean conditions on the Pacific, Atlantic and Arctic coasts of Canada, and provides an open-source data portal for researchers to understand ocean-and-planet sustainability and to support evidence-based decision-making.
“Temporal dynamics of the deep-sea pink urchin Strongylocentrotus fragilis on the Northeast Pacific continental margin” is published in the journal Deep-Sea Research Part I. Contact authors for a full copy.
Read about Fisheries and Oceans investment into UVic’s Ocean Networks Canada announced today.
Learn more about ONC’s latest advancements in ocean science and innovation. Advancing Canada’s science and innovation for ocean protection
-- 30 --
A media kit containing high-resolution photos and video is available here.
Photos
Media contacts
Robyn Meyer (Ocean Networks Canada) at 250-588-4053 or onc-comms@uvic.ca
Jennifer Kwan (University Communications + Marketing) at 250-721-7641 or uvicnews@uvic.ca